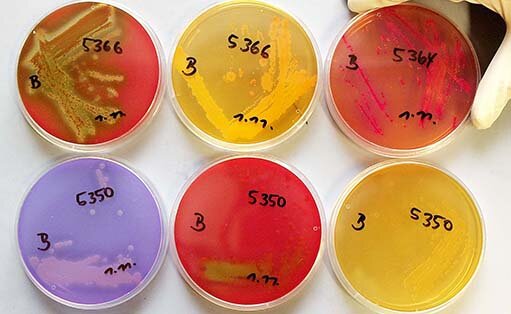

Externer Inhalt von Bundesamt für Kartographie und Geodäsie
Hier befinden sich externe Inhalte des Anbieters "Bundesamt für Kartographie und Geodäsie". Um diese anzeigen zu können benötigen wir Ihr Einverständnis.
Datenschutzrichtlinien
Externer Inhalt von Bundesamt für Kartographie und Geodäsie
Hier befinden sich externe Inhalte des Anbieters "Bundesamt für Kartographie und Geodäsie". Um diese anzeigen zu können benötigen wir Ihr Einverständnis.
Datenschutzrichtlinien
Diese Website nutzt Cookies, um das beste Nutzererlebnis zu gewährleisten, um die Nutzung der Website zu analysieren und Datenschutzeinstellungen zu speichern. In unseren Datenschutzrichtlinien können Sie Ihre Auswahl jederzeit ändern.
Diese Website nutzt Cookies, um das beste Nutzererlebnis zu gewährleisten, um die Nutzung der Website zu analysieren und Datenschutzeinstellungen zu speichern. In unseren Datenschutzrichtlinien können Sie Ihre Auswahl jederzeit ändern.
Funktionale
Diese Cookies gewährleisten das korrekte Betreiben der Seite. Auch zustimmungsfreie Cookies oder First Party Cookies genannt.
Anbieter, die Cookies auf dieser Seite nutzen, werden nachfolgend aufgelistet. Wo dies möglich ist, können Sie der Nutzung von Cookies zustimmen.
Cookies, welche für die Grundfunktion unserer Seite benötigt und gesetzt werden.
Speichert die Auswahl des Cookie-Managments.
Wird für die Funktionalität des Kontaktformulars benötigt.
Merkt sich das Schließen einer Informationsleiste damit diese beim nächsten Seitenaufruf nicht erneut angezeigt wird.
Dieses Cookie speichert die Auswahl des Kontrastmodus.
Cookies, welche für die Nutzung des TYPO3 Backendzugangs benötigt und gesetzt werden.
Speichert die Sitzungs-ID welche beim einloggen in das TYPO3-Backend erstellt wird und die Sitzung eindeutig identifiziert.
Speichert die Backend-User-ID welche beim einloggen in das TYPO3-Backend erstellt wird und den Nutzer eindeutig identifiziert.
Streaming-Dienste
Unsere Internetseite kann Elemente aus externen Quellen enthalten. Es wird darauf hingewiesen, dass wir keinen Einfluss darauf haben, dass Betreiber anderer Webseiten die geltenden Datenschutzbestimmungen einhalten. Weitere Informationen zu den einzelnen Anbietern finden Sie unter den detaillierten Informationen.
Anbieter, die Cookies auf dieser Seite nutzen, werden nachfolgend aufgelistet. Wo dies möglich ist, können Sie der Nutzung von Cookies zustimmen.
Karten-Dienste
Unsere Internetseite kann Elemente aus externen Quellen enthalten. Es wird darauf hingewiesen, dass wir keinen Einfluss darauf haben, dass Betreiber anderer Webseiten die geltenden Datenschutzbestimmungen einhalten. Weitere Informationen zu den einzelnen Anbietern finden Sie unter den detaillierten Informationen.
Anbieter, die Cookies auf dieser Seite nutzen, werden nachfolgend aufgelistet. Wo dies möglich ist, können Sie der Nutzung von Cookies zustimmen.
Externer Inhalt von ##teaserTitle##
##teaserText##